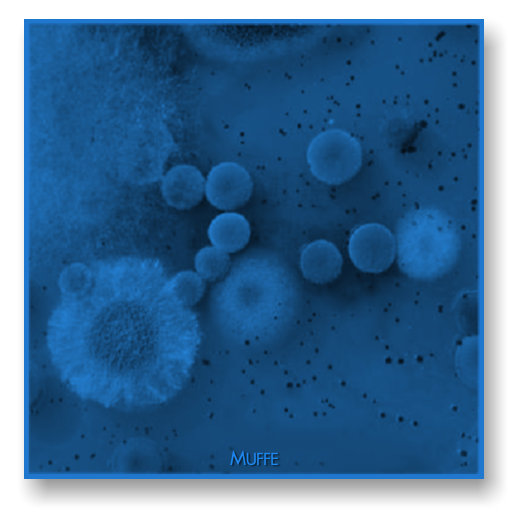

Analisi Microbiologiche 3 - ALIMENTAZIONE AMBIENTE Srl - Laboratorio ChimicoMicrobiologico - Roma (Italy)
Menu principale:
Analisi Microbiologiche 3
ANALISI
Analisi Microbiologiche 3

CONTROLLO DELLA QUALITA' DELL' ARIA
(CELLE DI STAGIONATURA, CELLE DI STOCCAGGIO, AMBIENTI DI LAVORAZIONE, UFFICI, CENTRI DI COTTURA)
Il prelievo di aria all'interno di locali di produzione mediante uno strumento (SAS) che ha la possibilita' di prelevare un volume di aria, convogliato su una piastra Petri, con terreno di accrescimento o selettivo, permette di determinare la concentrazione batterica nell'aria, al fine del controllo di eventuali ricontaminazioni degli alimenti processati nell'area controllata.
La legionellosi e' una malattia che puo' essere evitata attraverso un adeguato programma di manutenzione. L'indagine ambientale per la ricerca della Legionella permette di verificare i punti critici ed i focolai di infezione di Legionella in casi dichiarati e di verificare l'adeguatezza degli interventi di manutenzione e sanificazione.

A - CONTROLLO AMBIENTE CON SAS E PIASTRE A CONTATTO
(PARAMETRO)
- Carica microbica totale
- Coliformi totali
- Coliformi fecali

- Stafilococco coagulasi (+)

- Lieviti e Muffe
- Legionella

B - CONTROLLO POLVERI SOTTILI IN AMBIENTE OUTDOOR-INDOOR
Da qualche anno abbiamo iniziato, date le notevoli implicazioni sulla salute, la ricerca e lo studio delle polveri sottili.
Effetti sulla salute
Il particolato ha effetti diversi sulla salute umana ed animale a seconda dell'origine (naturale, antropica ecc.) e delle dimensioni delle polveri.
Tra i disturbi attribuiti al particolato fine e ultrafine (PM10 e soprattutto PM2.5. PM1 e PM0.1) vi sono patologie acute e croniche a carico dell'apparato respiratorio (asma, bronchiti, enfisema, allergia, tumori) e cardio-circolatorio (aggravamento dei sintomi cardiaci nei soggetti predisposti).
Polveri sottili o particolato atmosferico: PM10 e PM2,5 sono nomi diversi usati per indicare un particolare tipo di inquinamento atmosferico che puo' essere osservato e misurato.
Il PM10 e' il particolato atmosferico che ha un diametro uguale o inferiore a  mentre il PM2,5 ha un diametro uguale o inferiore a
mentre il PM2,5 ha un diametro uguale o inferiore a  .
.
 mentre il PM2,5 ha un diametro uguale o inferiore a
mentre il PM2,5 ha un diametro uguale o inferiore a  .
.Il PM2,5 detto anche particolato respirabile e' piu' pericoloso per la salute e l'ambiente rispetto alle PM10: questo particolato puo' rimanere sospeso nell'atmosfera per giorni o settimane.
Le particelle maggiori  rimangono in atmosfera da poche ore a pochi giorni, contribuiscono poco al numero di particelle in sospensione, ma molto al peso totale delle particelle in sospensione; sono significativamente meno dannose per la salute e l'ambiente.
rimangono in atmosfera da poche ore a pochi giorni, contribuiscono poco al numero di particelle in sospensione, ma molto al peso totale delle particelle in sospensione; sono significativamente meno dannose per la salute e l'ambiente.
 rimangono in atmosfera da poche ore a pochi giorni, contribuiscono poco al numero di particelle in sospensione, ma molto al peso totale delle particelle in sospensione; sono significativamente meno dannose per la salute e l'ambiente.
rimangono in atmosfera da poche ore a pochi giorni, contribuiscono poco al numero di particelle in sospensione, ma molto al peso totale delle particelle in sospensione; sono significativamente meno dannose per la salute e l'ambiente.Il PM2,5 e' una miscela complessa di migliaia di composti chimici e, alcuni di questi sono di estremo interesse a causa della loro tossicita'. L'attenzione e' rivolta agli idrocarburi aromatici policiclici (PHA) che svolgono un ruolo nello sviluppo del cancro; alcuni nomi: Fluorantrene, Pirene, Benz[a]antracene, Benzo[b]fluorantrene, Benzo[k]fluorantrene, Benzo[a]pirene, Dibenz[a,h]antracene.
Le concentrazioni di PM in atmosfera dipendono sia da sorgenti naturali che antropiche.
La concentrazione di fondo di PM e' solitamente definita come la distribuzione delle concentrazioni di PM che si osserverebbe in assenza di emissioni antropiche di PM (particelle primarie; si pensi che l'intervallo atteso per le concentrazioni naturali di fondo su base annuale varia da  per il PM2,5 nei luoghi remoti del Nord America.
per il PM2,5 nei luoghi remoti del Nord America.
 per il PM2,5 nei luoghi remoti del Nord America.
per il PM2,5 nei luoghi remoti del Nord America.
Siamo in grado di rilevare:
1) la presenza e/o assenza della Legionella e la qualita' dell'aria negli uffici (Carica microbica totale, Lieviti e Muffe, Legionella e Polveri sottili (PM10, PM PM2,5, PM1, PTS) al fine di valutare l'efficienza dei filtri e la qualita' dell'aria.
2) Testare la presenza di allergeni (Muffe e Lieviti) e la Legionella al fine di salvaguardare la salute ed il benessere degli occupanti gli uffici da allergie, accumuli di polveri sottili nei polmoni e dalla Legionellosi.
I limiti di legge per i livelli di particolato:
il PM10, ha una soglia annuale di  mentre quella giornaliera e' di
mentre quella giornaliera e' di  con un massimo di 35 "sforamenti" concessi nel corso di un anno.
con un massimo di 35 "sforamenti" concessi nel corso di un anno.
 mentre quella giornaliera e' di
mentre quella giornaliera e' di  con un massimo di 35 "sforamenti" concessi nel corso di un anno.
con un massimo di 35 "sforamenti" concessi nel corso di un anno.La novita' in materia e' che l'Unione Europea ha deciso di introdurre regole da rispettare anche per il PM2,5 cioe' per le polveri di diametro piu' piccolo, tutte in grado di penetrare l'albero respiratorio e di raggiungere gli alveoli polmonari; nell'aprile 2008 l'Unione Europea ha adottato definitivamente una nuova direttiva (2008/501EC) che detta limiti di qualita' dell'aria con riferimento anche alle PM2,5 che non dovranno superare i  nel 2010.
nel 2010.
 nel 2010.
nel 2010.